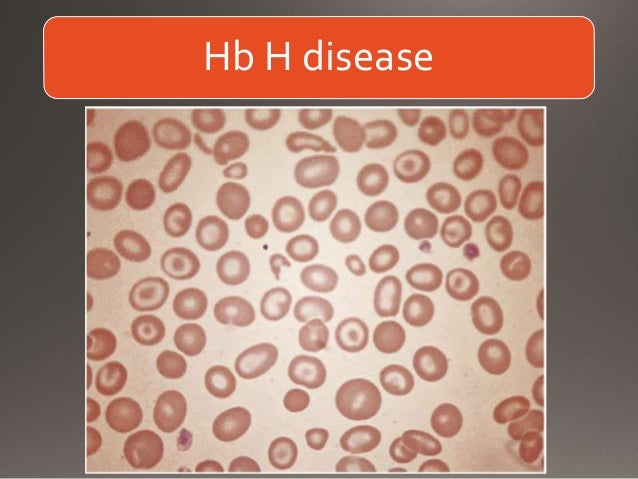

Update Hemoglobin Disease, Terbaru!
Topik menarik dari Update Hemoglobin Disease, Terbaru! adalah
hemoglobin adalah, hemoglobin abnormal adalah,

Hemoglobin Disease Hemoglobin Disease 8 Anemia Symptoms Types Causes Treatment merupakan Hemoglobin Disease dari : www.medicinenet.com

Hemoglobin Disease Hemoglobin Disease Hemoglobinopathies Lab diagnosis merupakan Hemoglobin Disease dari : www.slideshare.net

Hemoglobin Disease Hemoglobin Disease Sickle cell anemia An Overview merupakan Hemoglobin Disease dari : www.slideshare.net
Hemoglobin Disease Hemoglobin Low and High Range Causes Center MedicineNet
Hemoglobin Disease, Hemoglobin C is an abnormal type of hemoglobin the protein in red blood cells that carries oxygen It is a type of hemoglobinopathy The disease is caused by a problem with a gene called beta globin The disease most often occurs in African Americans You are more likely to have hemoglobin C disease if someone in your family has had it
Hemoglobin Disease Hemoglobin Disease Sickle cell disease Wikipedia merupakan Hemoglobin Disease dari : en.wikipedia.org
Hemoglobin Disease Low hemoglobin count Causes Mayo Clinic
Hemoglobin Disease, 23 07 2020 High hemoglobin count may be caused by dehydration smoking emphysema tumors or abuse of Epogen Low levels of hemoglobin may be caused by anemia blood loss nutritional deficiency bone marrow problems chemotherapy kidney failure or sickle cell disease Read more Hemoglobin Low and High Range Causes Article

Hemoglobin Disease Hemoglobin Disease Sickle Cell Anemia Hematology Medbullets Step 1 merupakan Hemoglobin Disease dari : step1.medbullets.com
Hemoglobin Disease Hemoglobin C S C and E Diseases Blood Disorders
Hemoglobin Disease, Hemoglobin C S C and E diseases are inherited conditions characterized by gene mutations that affect the hemoglobin the protein that carries oxygen in red blood cells causing the cells to shape themselves abnormally and clump together These red blood cells are destroyed more quickly than others resulting in chronic anemia
Hemoglobin Disease Hemoglobin Disease Sickle Cell Anaemia A Synopsis of the Inherited Ailment merupakan Hemoglobin Disease dari : www.archivesofmedicine.com

Hemoglobin Disease Hemoglobin Disease Thalassemia merupakan Hemoglobin Disease dari : www.slideshare.net
Hemoglobin Disease Hemoglobin Disease Alpha thalassemia merupakan Hemoglobin Disease dari : www.brown.edu
Hemoglobin Disease Hemoglobin Diseases Mississippi State Department of Health
Hemoglobin Disease,
hemoglobin adalah, hemoglobin abnormal adalah,

Hemoglobin Disease Hemoglobin Disease Hemoglobinopathies Lab diagnosis merupakan Hemoglobin Disease dari : www.slideshare.net
Hemoglobin Disease Hemoglobin Disease Sickle cell disease Wikipedia merupakan Hemoglobin Disease dari : en.wikipedia.org
Hemoglobin Disease Hemoglobin C Disease Lucile Packard Children s Hospital
Hemoglobin Disease,

Hemoglobin Disease Hemoglobin Disease Hemoglobinopathies Lab diagnosis merupakan Hemoglobin Disease dari : www.slideshare.net
Hemoglobin Disease Hemoglobin Disease Hemoglobinopathies Lab diagnosis merupakan Hemoglobin Disease dari : www.slideshare.net
Hemoglobin Disease Hemoglobin C disease MedlinePlus Medical Encyclopedia
Hemoglobin Disease,

Hemoglobin Disease Hemoglobin Disease About Sickle Cell Disease merupakan Hemoglobin Disease dari : www.augusta.edu
Hemoglobin Disease Hemoglobin E disease Genetic and Rare Diseases
Hemoglobin Disease, A slightly low hemoglobin count isn t always a sign of illness it may be normal for some people Women who are pregnant commonly have low hemoglobin counts Low hemoglobin counts associated with diseases and conditions A low hemoglobin count can be associated with a disease or condition that causes your body to have too few red blood cells
Hemoglobin Disease Hemoglobin Disease What is the mechanism of action of L glutamine for sickle merupakan Hemoglobin Disease dari : www.quora.com

Hemoglobin Disease Hemoglobin Disease Iron refractory iron deficiency anemia Genetics Home merupakan Hemoglobin Disease dari : ghr.nlm.nih.gov
Hemoglobin Disease Hemoglobin C Wikipedia
Hemoglobin Disease, 22 03 2020 Hemoglobin E HbE disease is a mild inherited blood disorder characterized by an abnormal form of hemoglobin called hemoglobin E People with this condition may have very mild anemia but the condition typically does not cause any symptoms It is inherited in an autosomal recessive manner and is caused by a mutation in the HBB gene The mutation that causes hemoglobin E disease
0 Komentar